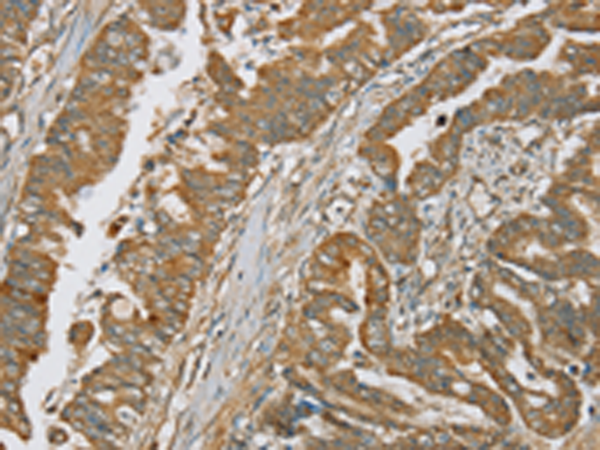

别名:C1IN; C1NH; HAE1; HAE2; C1INH应用:WB,IHC
反应种属:Human
规格:50μl/100μl
| Description |
|---|
| This gene encodes a highly glycosylated plasma protein involved in the regulation of the complement cascade. Its protein inhibits activated C1r and C1s of the first complement component and thus regulates complement activation. Deficiency of this protein is associated with hereditary angioneurotic oedema (HANE). Alternative splicing results in multiple transcript variants encoding the same isoform. |
| Specification | |
|---|---|
| Aliases | C1IN; C1NH; HAE1; HAE2; C1INH |
| Swissprot | P05155 |
| WB Predicted band size | 55 kDa |
| Host/Isotype | Rabbit IgG |
| Storage | Store at 4°C short term. Aliquot and store at -20°C long term. Avoid freeze/thaw cycles. |
| Species Reactivity | Human |
| Immunogen | Synthetic peptide of human SERPING1 |
| Formulation | pH7.4 PBS, 0.05% NaN3, 40% Glycerol |
| Application | |
|---|---|
| WB | 1/200-1/1000 |
| IHC | 1/25-1/100 |
| ELISA | 1/1000-1/2000 |
 |
Gel: 8%SDS-PAGE, Lysate: 40 μg, Lane: Human plasma tissue, Primary antibody: P05277(SERPING1 Antibody) at dilution 1/200, Secondary antibody: Goat anti rabbit IgG at 1/8000 dilution, Exposure time: 10 minutes |
|
The image is immunohistochemistry of paraffin-embedded Human esophagus cancer tissue using P05277(SERPING1 Antibody) at dilution 1/20. (Original magnification: ×200) |
本公司的所有产品仅用于科学研究或者工业应用等非医疗目的,不可用于人类或动物的临床诊断或治疗,非药用,非食用。
暂无评论
本公司的所有产品仅用于科学研究或者工业应用等非医疗目的,不可用于人类或动物的临床诊断或治疗,非药用,非食用。
 中文
中文 








发表回复